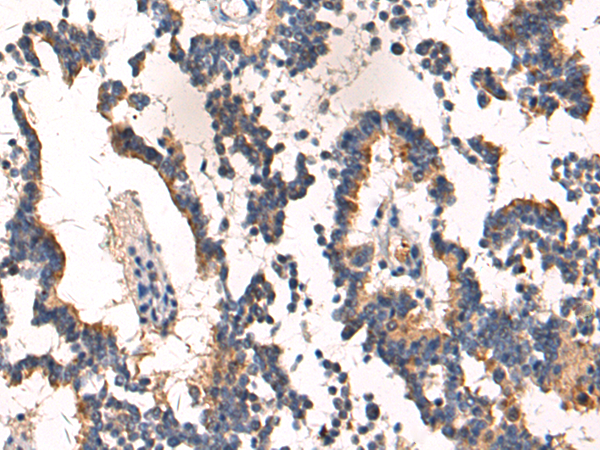

别名:SAG; GP340; SALSA; muclin应用:IHC
反应种属:Human, Mouse, Rat
规格:50μl/100μl
| Description |
|---|
| Loss of sequences from human chromosome 10q has been associated with the progression of human cancers. This gene was originally isolated based on its deletion in a medulloblastoma cell line. This gene is expressed with transcripts of 6.0, 7.5, and 8.0 kb in fetal lung and with one transcript of 8.0 kb in adult lung, although the 7.5 kb transcript has not been characterized. The encoded protein precursor is a glycoprotein containing multiple scavenger receptor cysteine-rich (SRCR) domains separated by SRCR-interspersed domains (SID). Transcript variant 2 (8.0 kb) has been shown to bind surfactant protein D independently of carbohydrate recognition. This indicates that DMBT1 may not be a classical tumor suppressor gene, but rather play a role in the interaction of tumor cells and the immune system. |
| Specification | |
|---|---|
| Aliases | SAG; GP340; SALSA; muclin |
| Swissprot | Q9UGM3 |
| Host/Isotype | Rabbit IgG |
| Storage | Store at 4°C short term. Aliquot and store at -20°C long term. Avoid freeze/thaw cycles. |
| Species Reactivity | Human, Mouse, Rat |
| Immunogen | Synthetic peptide of human DMBT1 |
| Formulation | pH7.4 PBS, 0.05% NaN3, 40% Glycerol |
| Application | |
|---|---|
| IHC | 1/50-1/100 |
| ELISA | 1/5000-1/10000 |
![]() |
The image is immunohistochemistry of paraffin-embedded Human tonsil tissue using P03875(DMBT1 Antibody) at dilution 1/50. (Original magnification: ×200) |
![]() |
The image is immunohistochemistry of paraffin-embedded Human liver cancer tissue using P03875(DMBT1 Antibody) at dilution 1/50. (Original magnification: ×200) |
本公司的所有产品仅用于科学研究或者工业应用等非医疗目的,不可用于人类或动物的临床诊断或治疗,非药用,非食用。
暂无评论
本公司的所有产品仅用于科学研究或者工业应用等非医疗目的,不可用于人类或动物的临床诊断或治疗,非药用,非食用。
中文

发表回复